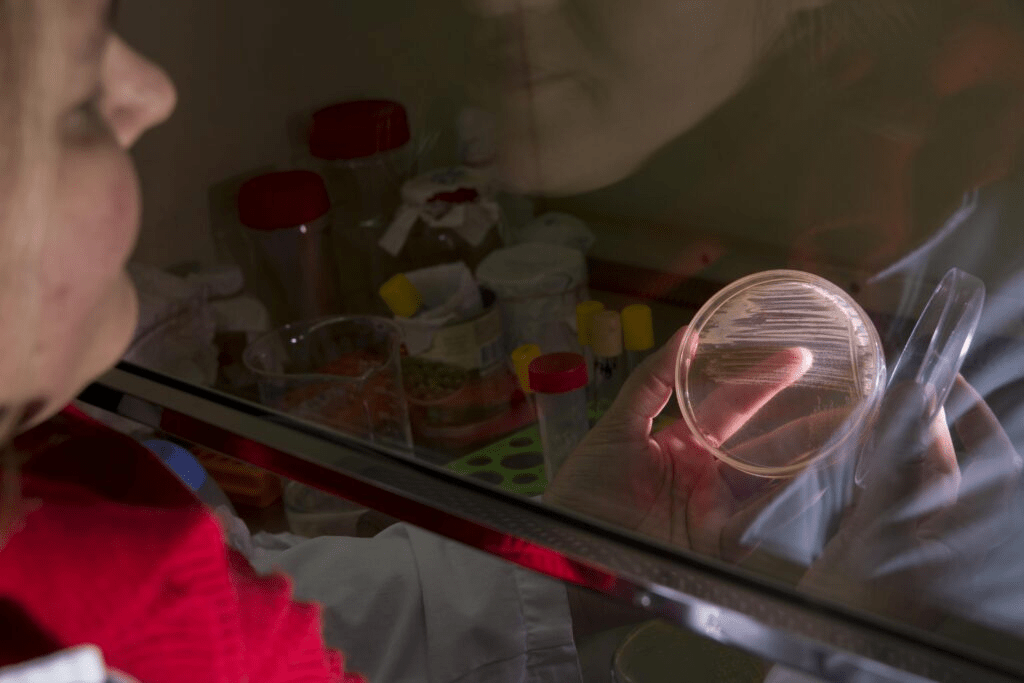

/Fuente: UNLP/
Un equipo internacional conformado por científicos de la Universidad Nacional de La Plata y de la Universidad de Manitoba, Canadá, reveló que existen sitios vulnerables en la estructura de las bacterias del complejo Burkholderia cepacia que pueden ser aprovechados como blancos para combatir estos microorganismos, a pesar de su multirresistencia a los antibioticos.
Las bacterias del complejo Burkholderia cepacia son de gran relevancia en nuestro país. Comprenden diversas especies que poseen una amplia distribución ambiental, una extraordinaria versatilidad metabólica, genomas complejos y de gran tamaño, y una alta tasa de mutación que les permite adaptarse rápidamente a diferentes entornos.
Además, presentan multi resistencia a los antibióticos y antisépticos, así como una notable capacidad para sobrevivir en condiciones de escasez de nutrientes, llegando incluso a utilizar ciertos antimicrobianos como fuente de carbono para su supervivencia. Estos rasgos son los que hacen que estas bacterias puedan contaminar exitosamente tanques de agua, formulados farmacéuticos y productos que contienen biocidas, además de representar un gran problema de salud pública al causar infecciones crónicas recalcitrantes y multirresistentes en personas con fibrosis quística, en pacientes hospitalizados y en individuos inmunocomprometidos.
En agosto del 2023, el equipo de la Dra. Silvia Cardona, investigadora argentina radicada en Canadá, Profesora del Departamento de Microbiología en la Universidad de Manitoba junto a la Dra. Alejandra Bosch y una de sus becarias, Dra. Beltina León, investigadoras del Centro de Investigación y Desarrollo en Fermentaciones Industriales (CINDEFI), dependiente de la Facultad de Ciencias Exactas de la UNLP y del CONICET, publicaron un importante artículo en la revista científica Nature Communications, titulado “Profiling cell envelope-antibiotic interactions reveals vulnerabilities to β-lactams in a multidrug-resistant bacterium”.
El trabajo desarrollado estudia la interacción de diferentes tipos de antibióticos con la envoltura celular de bacterias del Complejo Burkholderia cepacia. Esta investigación revela nuevas estrategias para combatir las infecciones por bacterias gram negativas multirresistentes a antibióticos.
“La envoltura celular de estos organismos constituye una barrera única que impide la penetración de antimicrobianos y son la principal causa de su múltiple resistencia. La resistencia intrínseca de estas bacterias a las diferentes clases de antimicrobianos limita severamente las opciones de tratamiento. Los antibióticos del grupo de los β-lactámicos constituyen hoy las armas más poderosas en la lucha contra estas especies bacterianas. Sin embargo, las tazas de resistencia se han ido incrementando en el tiempo y actualmente son mayores al 50%, incluso cuando se los combina con potenciadores como tazobactam o avibactam. Esta investigación, buscó intervenir en la mejora de las terapias antimicrobianas para combatir estas bacterias multirresistentes”, explicó la Doctora Bosch.
El trabajo presenta los resultados de un estudio genómico a gran escala que permitió identificar elementos de resistencia y susceptibilidad asociados a la envoltura celular en organismos del Complejo Burkholderia cepacia. El estudio se llevó a cabo a través de la creación de una biblioteca con miles de mutantes aleatorios diferentes, obtenida a través de la inserción de un transposón que contiene un código de barras. Estos códigos de barras son secuencias cortas de ADN que actúan como etiquetas específicas para cada mutante.
“Esta librería de 340.000 mutantes se desafió con más de 20 antimicrobianos y se estudió luego la respuesta utilizando secuenciación genómica para leer los códigos de barras de ADN de los mutantes que sobrevivieron a tal exposición (BarSeq). Así los datos de BarSeq se utilizaron para identificar los mutantes (los genes), relacionados con resistencia a los antimicrobianos. Se descubrió que muchas funciones de la envoltura celular están conectadas por una molécula llamada fosfato de undecaprenilo (UndP). Cuando se bloquea el metabolismo de esta molécula, las bacterias se vuelven más susceptibles a los antibióticos del grupo de los β-lactámicos”, detalló la científica de la UNLP.

En el proyecto se describió también que la sinergia de la combinación de los antimicrobianos ceftazidima con avibactam se basa en la inhibición de la enzima β-lactamasa PenB carbapenemasa. Es decir que la ceftazidima, un antibiótico β-lactámico, puede mantener su actividad antimicrobiana contra estas bacterias porque el segundo antimicrobiano avibactam, evita que la PenB carbapenemasa producida por estas bacterias descompongan a la ceftazidima. En base a estos resultados se demostró que avibactam potencia más fuertemente a otros β-lactámicos como aztreonam y meropenem para inhibir aislamientos clínicos del Complejo Burkholderia cepacia. Estas combinaciones no se informan comúnmente para el tratamiento de la infección por estos organismos, por lo que podrían representar enfoques terapéuticos alternativos que podrían resultar altamente beneficiosos en la práctica médica.
Bosch agregó, “también se describió por primera vez en organismos del Complejo Burkholderia cepacia la interacción del nuevo antimicrobiano cefiderocol con la envoltura celular de estas bacterias. Se demostró que más del 85% de los aislamientos clínicos ensayados fueron sensibles a este nuevo antibiótico. Estos resultados pueden tener un impacto en el avance del uso de esta nueva droga, ya que aún no está indicada para el tratamiento de infecciones crónicas en fibrosis quística”.
Cabe destacar que desde hace 20 años el equipo de investigación del laboratorio de “Biofilms Microbianos”, del CINDEFI de Facultad de Ciencias Exactas y CONICET ha estado dedicado al estudio de estrategias de adaptación empleadas por los organismos del Complejo Burkholderia cepacia para persistir en infecciones pulmonares crónicas de personas con FQ y del ambiente hospitalario.
Por otro lado, el grupo dirigido por la Dra. Silvia Cardona posee gran trayectoria internacional en genética bacteriana. Su línea de investigación ha sido la aplicación de técnicas de biología molecular, el desarrollo de herramientas genómicas para la construcción de librerías de mutantes por transposición y técnicas de biología sintética basadas en CRISPRi.
A partir del año 2019, en el marco del Programa de Intercambio del Gobierno de Canadá entre estudiantes e investigadores de ambos grupos, y el apoyo del Ministerio Nacional de Ciencia y Tecnología de nuestro país fue posible crear y fortalecer un fructífero grupo interdisciplinario de investigación. En primer lugar, la visita de la Dra. Silvia Cardona al laboratorio de la Dra. Bosch, posteriormente mediante una pasantía en Canadá, la Dra. Beltina León (becaria CONICET) se incorporó al grupo de trabajo de la Dra. Cardona en la Universidad de Manitoba. Beltina, junto con Andrew Hogan, Zisanur Rahman y Dustin Maydaniuk lograron construir un grupo de trabajo joven fortalecido por la amistad y la pasión por la investigación en un tema tan fascinante y desafiante como lo es combatir las bacterias multirresistentes.
Este trabajo de cooperación internacional permitió avanzar en la investigación científica en un tema que hoy tiene implicancias directas para el tratamiento de las infecciones crónicas por organismo multirresistentes, temática considerada de alta prioridad mundial para la OMS.
Vale remarcar que este desarrollo recientemente fue seleccionado por Nature Communications Editors’ Highlights entre los 50 artículos destacados publicados en el área de microbiología y enfermedades infecciosas en el último tiempo por su contribución en promover la comprensión del mundo microbiano https://www.nature.com/collections/jedgcgeija.